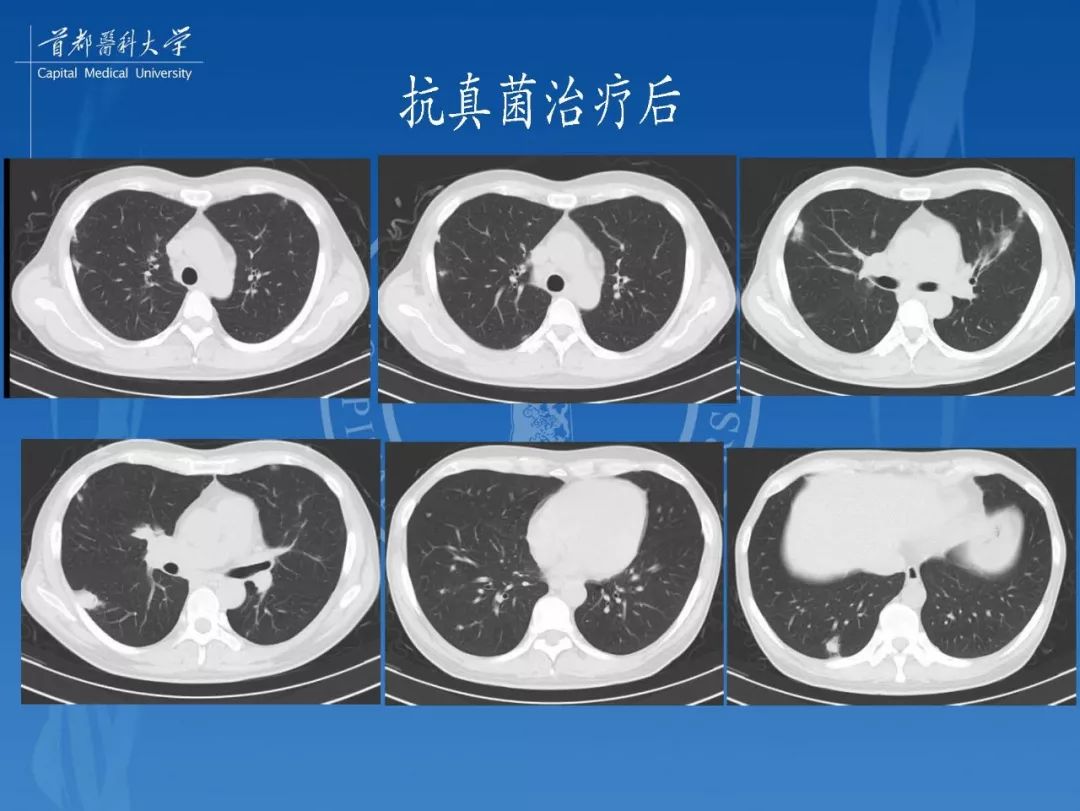
结核性肉芽肿结节的影像特点和鉴别诊断

结核性肉芽肿图片

肺结核融合性肉芽肿
图片尺寸316x479结核性肉芽肿——王钦习老师分享(感谢)!
图片尺寸601x800
比如digeorge综合征,wiskott-aldrich综合征,高igm综合征,慢性肉芽肿
图片尺寸576x346
结核性肉芽肿结节的影像特点和鉴别诊断
图片尺寸1080x811
典型图片化脓性肉芽肿
图片尺寸514x281
肺结核(结核性肉芽肿)
图片尺寸1123x816病理实验结核性肉芽肿
图片尺寸1080x571
结核性肉芽肿结节的影像特点和鉴别诊断
图片尺寸1080x811
结核性肉芽肿结节的影像特点和鉴别诊断
图片尺寸1080x811
肺结核性肉芽肿,脾粟粒性肉芽肿
图片尺寸323x504
今日病例模仿丘疹坏死性结核疹的环状肉芽肿亚型
图片尺寸640x564
结核性肉芽肿结节的影像特点和鉴别诊断
图片尺寸1080x811
图9: 胸膜活检病理可见结核肉芽肿
图片尺寸910x680结核性肉芽肿
图片尺寸400x274生物病理显微镜切片结核性肉芽肿标本白底显微摄影教学素材
图片尺寸1200x762生物病理显微镜切片结核性肉芽肿标本白底显微摄影教学素材
图片尺寸1200x762
『 what matters in life is not - 抖音
图片尺寸1080x849
结核性肉芽肿结节的影像特点和鉴别诊断
图片尺寸1080x811
结核肉芽肿.朗格罕斯细胞
图片尺寸700x567肺结核非坏死性肉芽肿
图片尺寸640x488
猜你喜欢:结核性肉芽肿病理绘图结核性肉芽肿手绘图结核性肉芽肿结核性肉芽肿切片结核性肉芽肿绘图结核性肉芽肿切片绘图结核性肉芽肿手绘结核性肉芽肿镜下图结核性肉芽肿红蓝化脓性肉芽肿图片结核性肉芽肿红蓝绘图结核性肉芽肿显微镜结核性溃疡图片肉芽肿性乳腺炎图片结核肉芽肿结核性肉芽肿镜下描述肉芽肿图片结核肉芽肿病理绘图结核性口腔溃疡图片结核性肉芽肿红蓝铅笔肉芽肿初期图片麦粒肿肉芽肿图片皮肤肉芽肿图片眼睛肉芽肿图片感染性肉芽肿化脓性肉芽肿化脓性肉芽肿初期肉芽肿性炎伤寒肉芽肿手绘图肉芽肿性乳腺炎个人设计作品集肉桂狗壁纸敌人草敌人打图片索隆大千世界图片一根绳子编头绳8888的红包图片大全动画人物拟人化大全三国杀廖化小富婆头像动漫社会基本矛盾交警驾驶警车的图片戴琳资料